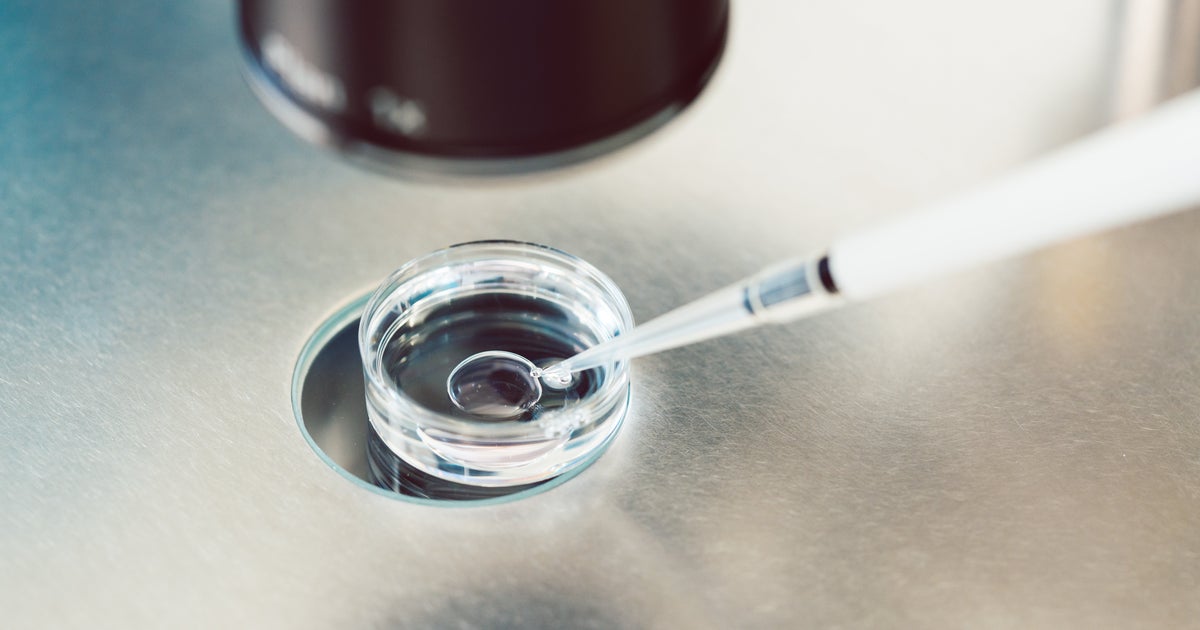

With Apple Giving Up On iTunes, Is It The Demise Of Downloading?
The implications across sectors of the media and entertainment industry could be significant. So does the expected announcement indeed signal a turning point for the industry to fully embrace streaming, leading to the demise of downloading? So it's fair to say that we have been moving to the streaming era, and with Apple giving up on iTunes, some will predict the demise of downloading or its fast path to oblivion, joining CD distribution. Note that in countries with very high bandwidth capability like South Korea and Japan, music revenues from dowloading are actually going up. So Apple can give up on iTunes but it should not give up on downloading.
Source: Forbes June 01, 2019 00:48 UTC